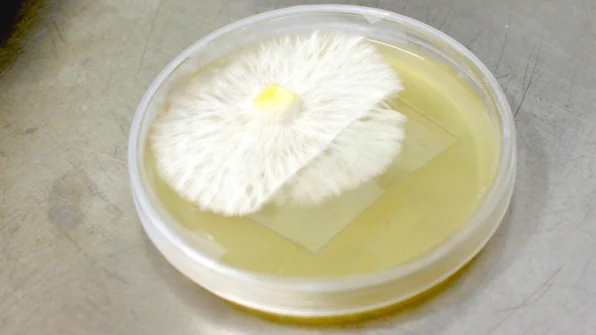
Nấm có thể là vật liệu cách nhiệt cho ngôi nhà của bạn trong tương lai Nấm có thể là vật liệu cách nhiệt cho ngôi nhà của bạn trong tương lai

VNR Content
Pearl
Hãng Biohm trồng nấm bằng chất thải nông nghiệp, sau đó sử dụng mycelium, loại rễ giống sợi chỉ vốn kết nối nấm lại với nhau, để làm ra những tấm cách nhiệt hiệu quả mà vẫn thân thiện môi trường.
Mỗi khi một toà nhà được xây dựng nên, hay bị phá bỏ đi, những chiếc xe rác chở đầy rác thải xây dựng lại nối đuôi nhau đến điểm tập kết rác - và mỗi năm tại Mỹ, ngành công nghiệp xây dựng và phá dỡ tạo ra lượng rác gấp đôi so với tổng số các loại rác thải khác trong các thành phố. Vật liệu xây dựng thường cũng không thể được tái chế một cách dễ dàng. Nhưng bằng cách tái thiết kế các vật liệu thông dụng, một startup tại Anh tên là Biohm hứa hẹn sẽ giúp ngành công nghiệp này dịch chuyển sang mô hình xoay vòng với nhiều lợi ích về lâu dài.
Tại một nhà máy dự kiến sẽ mở cửa vào đầu năm sau, cách London vài giờ về phía tây, Biohm sẽ sớm bắt đầu sản xuất hàng loạt sản phẩm đầu tiên của hãng: vật liệu cách nhiệt từ mycelium, một loại rễ dạng sợi kết nối các quần thể nấm với nhau. Vật liệu có khả năng tự huỷ sinh học này chính là câu trả lời cho những vấn đề môi trường gây ra bởi vật liệu cách nhiệt cao su bọt thông thường. Nhưng trên thực tế, hiệu quả của nó còn vượt trội hơn cả người đi trước.
 “Chúng tôi phát hiện ra rằng mycelium, hay các mạng lưới và cấu trúc nấm, cực kỳ tương đồng với các cấu trúc mà bạn thấy trong những sản phẩm cách nhiệt bằng nhựa nhân tạo” - Ehab Sayed, nhà sáng lập kiêm giám đốc cải tiến tại Biohm, cho biết. Trong các bài test, họ nhận thấy vật liệu này có khả năng cách nhiệt tốt hơn hẳn những vật liệu thay thế như cao su bọt nhờ đặc tính dẫn nhiệt kém hơn, và trong trường hợp hoả hoạn, nó cũng cháy chậm hơn. Các bài test còn cho thấy nó bền ngang ngửa vật liệu cách nhiệt tiêu chuẩn. Nhưng không như vật liệu cách nhiệt tiêu chuẩn, nó có thể được biến thành phân trộn một cách an toàn khi đã đi đến cuối vòng đời, hoặc dễ dàng được tái sử dụng để làm nên nhiều vật liệu cách nhiệt hơn nữa.
“Chúng tôi phát hiện ra rằng mycelium, hay các mạng lưới và cấu trúc nấm, cực kỳ tương đồng với các cấu trúc mà bạn thấy trong những sản phẩm cách nhiệt bằng nhựa nhân tạo” - Ehab Sayed, nhà sáng lập kiêm giám đốc cải tiến tại Biohm, cho biết. Trong các bài test, họ nhận thấy vật liệu này có khả năng cách nhiệt tốt hơn hẳn những vật liệu thay thế như cao su bọt nhờ đặc tính dẫn nhiệt kém hơn, và trong trường hợp hoả hoạn, nó cũng cháy chậm hơn. Các bài test còn cho thấy nó bền ngang ngửa vật liệu cách nhiệt tiêu chuẩn. Nhưng không như vật liệu cách nhiệt tiêu chuẩn, nó có thể được biến thành phân trộn một cách an toàn khi đã đi đến cuối vòng đời, hoặc dễ dàng được tái sử dụng để làm nên nhiều vật liệu cách nhiệt hơn nữa.
Được biết, Biohm trồng mycelium bằng các phụ phẩm nông nghiệp từ nấm, giúp sản phẩm cuối cùng trở thành âm carbon. Sau đó, họ để nó phát triển to lên thành kích cỡ của một tấm cách nhiệt tiêu chuẩn. “Thứ bạn thu được là một tấm cách nhiệt hoàn toàn được hình thành một cách tự nhiên”, Sayed nói. Một khi mycelium đã phát triển đến kích cỡ mong muốn, nó sẽ được lưu hoá thành một vật liệu bền, chắc.
 Nhờ có nguồn gốc từ nấm, loại vật liệu mới tránh được nhiều hạn chế. Vật liệu cách nhiệt cao su bọt thông thường có gốc nhiên liệu hoá thạch, mà theo Sayed là có thể góp phần gây suy giảm tài nguyên, và quá trình sản xuất ra nó còn xả thải carbon cũng như tiêu tốn nhiều năng lượng. Các sản phẩm này cũng thường được làm bằng một loại khí gas có ảnh hưởng đến khi hậu nhiều hơn cả CO2, dù ngành công nghiệp hiện đang tung ra những sản phẩm thay thế mới hơn để giải quyết vấn đề. Các sản phẩm khác ban đầu có thể sử dụng các vật liệu tự nhiên, nhưng sau đó lại được thêm vào formaldehyde và các hoá chất độc hại khác như các chất ngăn bắt lửa. Tại các công trường xây dựng, bụi từ việc cắt các vật liệu cách nhiệt có thể rất độc hại cho công nhân; kể cả trong nhà, vật liệu cách nhiệt này có thể thải ra các hợp chất hữu cơ không đoán trước được, khiến chất lượng không khí trong nhà bị suy giảm.
Nhờ có nguồn gốc từ nấm, loại vật liệu mới tránh được nhiều hạn chế. Vật liệu cách nhiệt cao su bọt thông thường có gốc nhiên liệu hoá thạch, mà theo Sayed là có thể góp phần gây suy giảm tài nguyên, và quá trình sản xuất ra nó còn xả thải carbon cũng như tiêu tốn nhiều năng lượng. Các sản phẩm này cũng thường được làm bằng một loại khí gas có ảnh hưởng đến khi hậu nhiều hơn cả CO2, dù ngành công nghiệp hiện đang tung ra những sản phẩm thay thế mới hơn để giải quyết vấn đề. Các sản phẩm khác ban đầu có thể sử dụng các vật liệu tự nhiên, nhưng sau đó lại được thêm vào formaldehyde và các hoá chất độc hại khác như các chất ngăn bắt lửa. Tại các công trường xây dựng, bụi từ việc cắt các vật liệu cách nhiệt có thể rất độc hại cho công nhân; kể cả trong nhà, vật liệu cách nhiệt này có thể thải ra các hợp chất hữu cơ không đoán trước được, khiến chất lượng không khí trong nhà bị suy giảm.
 Biohm, vốn là một trong những cái tên giành được giải thưởng Index Award 2021 (giải thưởng tập trung vào tác động xã hội), đồng thời đang phát triển các vật liệu xây dựng xanh khác, bao gồm xi măng gốc thực vật và một loại ván sợi mới làm từ thức ăn thừa. Hãng còn dự định tung ra một hệ thống xây dựng xoay vòng mới sử dụng kết hợp mọi loại vật liệu. Tiếp đó, họ còn có kế hoạch mở nhiều nhà máy mới tại Anh và Hà Lan.
Biohm, vốn là một trong những cái tên giành được giải thưởng Index Award 2021 (giải thưởng tập trung vào tác động xã hội), đồng thời đang phát triển các vật liệu xây dựng xanh khác, bao gồm xi măng gốc thực vật và một loại ván sợi mới làm từ thức ăn thừa. Hãng còn dự định tung ra một hệ thống xây dựng xoay vòng mới sử dụng kết hợp mọi loại vật liệu. Tiếp đó, họ còn có kế hoạch mở nhiều nhà máy mới tại Anh và Hà Lan.
 Nhà máy hiện tại của Biohm sẽ sản xuất vật liệu cách nhiệt mới ở quy mô nhỏ, đủ cho khoảng 30 hộ gia đình mỗi tháng. Dẫu vậy, khi những sản phẩm đầu tiên được xuất xưởng, giá của chúng vẫn đủ sức để cạnh tranh với các vật liệu cách nhiệt cao cấp hơn. Khi công ty mở rộng quy mô sản xuất, chi phí sẽ giảm xuống, giúp sản phẩm trở nên dễ tiếp cận hơn đối với các họ gia đình trung bình. Việc công ty sử dụng rác thải cũng giúp giảm phần nào chi phí. “Hai nguyên liệu duy nhất là chất thải từ nguyên liệu cấp cho máy để chế biến, vốn là loại chất thải mà chúng tôi thu thập thông qua một dịch vụ thu thập rác thải, và mycelium, thứ được chúng tôi tự nuôi trồng trong các phân xưởng. Do đó về cơ bản bạn không phải trả chi phí cho bất kỳ vật liệu thô nào, giúp mọi thứ dễ dàng thực hiện hơn khi sản xuất ở quy mô lớn”, Sayed nói.
Nhà máy hiện tại của Biohm sẽ sản xuất vật liệu cách nhiệt mới ở quy mô nhỏ, đủ cho khoảng 30 hộ gia đình mỗi tháng. Dẫu vậy, khi những sản phẩm đầu tiên được xuất xưởng, giá của chúng vẫn đủ sức để cạnh tranh với các vật liệu cách nhiệt cao cấp hơn. Khi công ty mở rộng quy mô sản xuất, chi phí sẽ giảm xuống, giúp sản phẩm trở nên dễ tiếp cận hơn đối với các họ gia đình trung bình. Việc công ty sử dụng rác thải cũng giúp giảm phần nào chi phí. “Hai nguyên liệu duy nhất là chất thải từ nguyên liệu cấp cho máy để chế biến, vốn là loại chất thải mà chúng tôi thu thập thông qua một dịch vụ thu thập rác thải, và mycelium, thứ được chúng tôi tự nuôi trồng trong các phân xưởng. Do đó về cơ bản bạn không phải trả chi phí cho bất kỳ vật liệu thô nào, giúp mọi thứ dễ dàng thực hiện hơn khi sản xuất ở quy mô lớn”, Sayed nói.
Tham khảo: FastCompany
Mỗi khi một toà nhà được xây dựng nên, hay bị phá bỏ đi, những chiếc xe rác chở đầy rác thải xây dựng lại nối đuôi nhau đến điểm tập kết rác - và mỗi năm tại Mỹ, ngành công nghiệp xây dựng và phá dỡ tạo ra lượng rác gấp đôi so với tổng số các loại rác thải khác trong các thành phố. Vật liệu xây dựng thường cũng không thể được tái chế một cách dễ dàng. Nhưng bằng cách tái thiết kế các vật liệu thông dụng, một startup tại Anh tên là Biohm hứa hẹn sẽ giúp ngành công nghiệp này dịch chuyển sang mô hình xoay vòng với nhiều lợi ích về lâu dài.
Tại một nhà máy dự kiến sẽ mở cửa vào đầu năm sau, cách London vài giờ về phía tây, Biohm sẽ sớm bắt đầu sản xuất hàng loạt sản phẩm đầu tiên của hãng: vật liệu cách nhiệt từ mycelium, một loại rễ dạng sợi kết nối các quần thể nấm với nhau. Vật liệu có khả năng tự huỷ sinh học này chính là câu trả lời cho những vấn đề môi trường gây ra bởi vật liệu cách nhiệt cao su bọt thông thường. Nhưng trên thực tế, hiệu quả của nó còn vượt trội hơn cả người đi trước.

Được biết, Biohm trồng mycelium bằng các phụ phẩm nông nghiệp từ nấm, giúp sản phẩm cuối cùng trở thành âm carbon. Sau đó, họ để nó phát triển to lên thành kích cỡ của một tấm cách nhiệt tiêu chuẩn. “Thứ bạn thu được là một tấm cách nhiệt hoàn toàn được hình thành một cách tự nhiên”, Sayed nói. Một khi mycelium đã phát triển đến kích cỡ mong muốn, nó sẽ được lưu hoá thành một vật liệu bền, chắc.

Tham khảo: FastCompany









